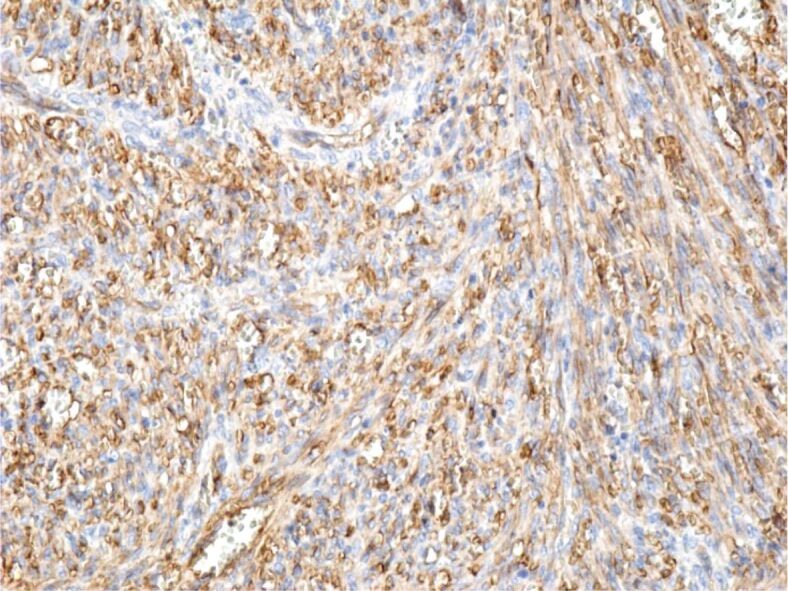

Kaposi's sarcoma of the larynx: case series.
IF 1.5
4区 医学
Q4 DEVELOPMENTAL BIOLOGY
引用次数: 0
Abstract
Kaposi's sarcoma (KS) represents a type of cancer that usually arises on the skin and very rarely in other organs. KS-associated herpesvirus (KSHV), also known as human herpesvirus-8 (HHV-8) commonly arises in patients with acquired immunodeficiency syndrome (AIDS). Laryngeal involvement of KS is very rare. Our study comprised of three cases with laryngeal KS. All cases were solved through surgical excision of the tumor. Histopathological and immunohistochemistry examinations revealed laryngeal KS. Laryngeal KS should be managed through surgical resection, followed by oncological treatment.

喉部卡波西肉瘤:病例系列。
卡波西肉瘤(KS)是一种癌症,通常发生在皮肤上,极少发生在其他器官。KS相关疱疹病毒(KSHV)又称人类疱疹病毒-8(HHV-8),常见于获得性免疫缺陷综合征(艾滋病)患者。KS 喉部受累非常罕见。我们的研究包括三例喉 KS 病例。所有病例均通过外科手术切除肿瘤。组织病理学和免疫组化检查显示喉 KS。喉 KS 应通过手术切除,然后进行肿瘤治疗。
本文章由计算机程序翻译,如有差异,请以英文原文为准。
求助全文
约1分钟内获得全文
求助全文
来源期刊

Romanian Journal of Morphology and Embryology
DEVELOPMENTAL BIOLOGY-
CiteScore
1.70
自引率
20.00%
发文量
221
审稿时长
3-8 weeks
期刊介绍:
Romanian Journal of Morphology and Embryology (Rom J Morphol Embryol) publishes studies on all aspects of normal morphology and human comparative and experimental pathology. The Journal accepts only researches that utilize modern investigation methods (studies of anatomy, pathology, cytopathology, immunohistochemistry, histochemistry, immunology, morphometry, molecular and cellular biology, electronic microscopy, etc.).
 求助内容:
求助内容: 应助结果提醒方式:
应助结果提醒方式:


